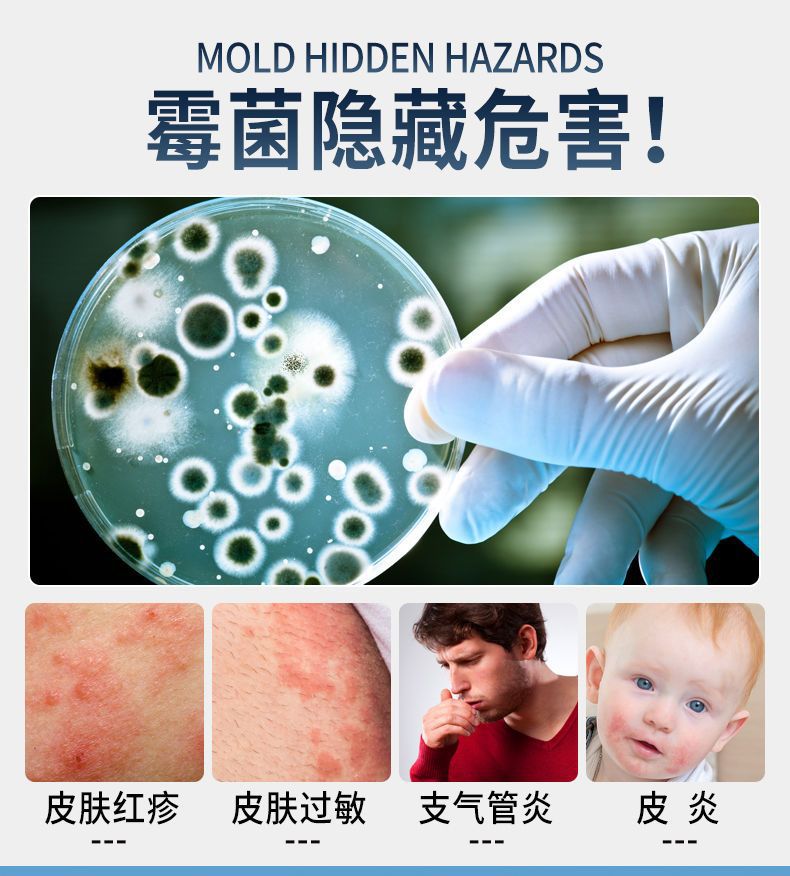

Удалитель плесени для одежды, желтая плесень, пятна плесени, белая одежда, обувь, тележка, очиститель стен шкафа
Цена
¥1.50 / ≈ 19 ₽
MOQ: 1 pcs
1шт - ¥1.50
Продавец
山东蕴之梦生物科技发展有限公司
Рейтинг
4.8
Продано
1
Всего
В наличии
164805
SKU суммарно
Offer ID: 713444379726
Оформить заказ
Цветовая классификация:
| Изображение | Цветовая классификация | Цена (CNY / RUB) | В наличии | SKU ID | Кол-во / Корзина |
|---|---|---|---|---|---|
 | 100ml clothing mildew remover | ¥1.5 / ≈ 19 ₽ | 28997 | 6018384615192 | |
 | 288ml clothing mildew remover | ¥2.4 / ≈ 31 ₽ | 65864 | 6018384615191 | |
 | 500ml clothing mildew remover | ¥3.0 / ≈ 39 ₽ | 69944 | 6018384615190 |
Статистика продавца
4.0
Сервис
Источник: API 1688
3.5
Логистика
Источник: API 1688
5.0
Споры
Источник: API 1688
5.0
Оформление
Источник: API 1688
3.0
Консультация
Источник: API 1688
48%
Повторные покупки
Источник: API 1688
3.6
Постпродажное
Источник: API 1688
100%
Ответ ≤48ч (30д)
Источник: API 1688
0%
Возврат по качеству (30д)
Источник: API 1688
Свойства товара
Бренд Strange
Нужно ли импортировать No
Тип бренда Domestic brand
Происхождение Shandong
Объем нетто 288ml
Брутто-Вес 340g
Номер товара Clothes mildew remover 288ml
Количество в коробке 60 bottles
Основные downstream платформы wish, Aliexpress, Independent station, LAZADA, Other
Основная зона продаж South america, Southeast asia, North america, Northeast asia, Middle east, Other
Существуют лицензируемые частные бренды Is
Будет ли поставка товаров исключительно для трансграничного экспорта Is
Категория продукта Wall mildew remover
Серия продукта Clothing
Описание товара